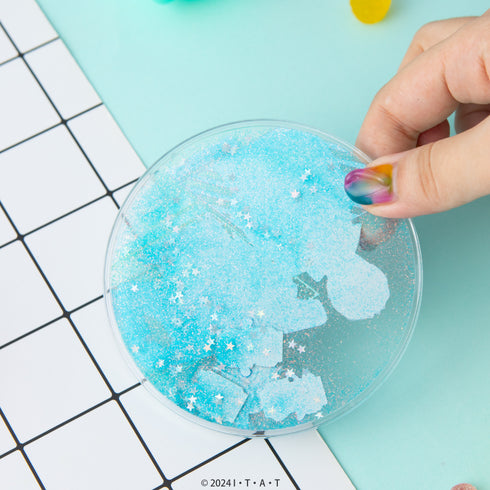
『仮面ライダーガヴ』グリッターコースター 03.仮面ライダーヴラム/ラキア・アマルガ【202512再販】

『仮面ライダーガヴ』グリッターコースター 03.仮面ライダーヴラム/ラキア・アマルガ【202512再販】
予約商品
©2024 石森プロ·テレビ朝日·ADK EM・東映
傾けるたびにグリッターが揺れる可愛いアイテム!中にはゴチゾウのフレークが入っています!
・モニターの仕様などにより写真と商品の色が多少異なる場合があります。予めご了承ください。
※当店で販売しているすべてのグリッター商品の中の液体は【ホワイトオイル】と呼ばれる皮膚などに付着した場合でも火傷など生じることのない、化粧水などにも使用されている人体に害のない安全性の高いオイルでございます。
・外気温とオイルの温度差により中に気泡が発生してしまう場合がございます。発生した場合は冷凍庫へ1日ほど入れれば気泡が消滅しますのでお試しください。(冷凍庫にいれても完全には凍りません。)
【商品についての注意点】
・本商品は、輸入時に発生する若干の擦りやごく僅かな小キズがある場合がございます。
■予約受付期間:〜2026年1月4日(日)
■発売時期:2026年01月20日ころ予定
■お届け予定:2026年1月下旬予定
■サイズ:φ110mm×D8mm
■素材:本体(ポリカーボネート)/カバー(シリコン)
■発売元:MAW
※予約商品は、予約受付期間終了後のキャンセルはお受けできません。
※予約期間の記載があり既に終了している商品、または予約期間の記載がない予約商品につきましても、キャンセルは承っておりません。
※予約商品は、ご注文時点で決済が確定いたします。
※発売予定時期が異なる商品を同時にご購入いただいた場合は、すべての商品が揃い次第の発送となります。
※発売済み商品を先にお届け希望の場合は、発売時期ごとに分けてご注文ください。
※メーカー都合により、発売日が延期となる場合がございます。
※発売遅延が発生した場合でも、キャンセルの対象とはなりません。
※ご予約受付期間内であっても、在庫状況や販売状況により、予告なく予約受付を終了する場合がございます。
※掲載画像はイメージです。実際の商品とは色味や仕様が異なる場合がございます。
※仕様・デザインは予告なく変更となる場合がございます。
6,600円(税込)以上のご購入で送料無料
4570143957302
販売元: MAW